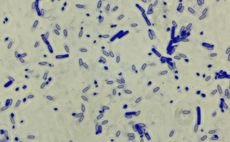

Leibniz-Institut für Pflanzengenetik und Kulturpflanzenforschung (IPK)

Interview mit Leon
Über eine Online-Ausbildungsplattform bin ich auf die Stellenanzeige gestoßen. Nach meiner Bewerbung bekam ich ziemlich schnell eine Rückmeldung und mir wurde ein Praktikum angeboten, das ich natürlich angenommen habe.
Das hat mir geholfen, das Unternehmen besser kennenzulernen, und danach war die Entscheidung für die Ausbildung klar.
Mein Wunsch war es, ein Unternehmen in meiner Region zu finden – das hat geklappt. Ich habe mir ein freundliches Arbeitsumfeld und interessante Aufgaben erhofft, und beides ist definitiv gegeben.
Die Arbeit in meiner Abteilung ist abwechslungsreich und ich lerne ständig neue Dinge dazu, die mich weiterbringen.
Am meisten Spaß macht mir die Zusammenarbeit mit den Kollegen im Team. Die praktischen Aufgaben wie Systemkonfiguration und Netzwerkarbeiten finde ich super, weil jeden Tag was anderes anfällt.
Was mich manchmal nervt, sind Situationen, wo man etwas länger auf Rückmeldungen warten muss und deshalb nicht weiterkommt.
Ich wurde von Anfang an gut ins Team aufgenommen und nicht als "nur Azubi" behandelt. Mein Ausbilder nimmt sich immer Zeit für Fragen, und wenn irgendwo Probleme auftauchen, wird direkt gemeinsam nach Lösungen gesucht.
Ich fühle mich gut betreut und kann viel lernen.
· Interesse und Eigeninitiative zeigen: Grundwissen mit PCs und Technik erleichtert den Einstieg auf jeden Fall, aber man muss kein Profi sein. Wichtig ist, dass man Bock hat zu lernen und sich reinzuhängen
· Keine Scheu vor Fragen haben: Lieber einmal mehr fragen als irgendwas falsch machen – die Kollegen helfen gerne weiter
· Teamfähigkeit mitbringen: Man arbeitet viel zusammen, da ist es wichtig, dass man gut im Team klarkommt
· Offen für verschiedene Aufgaben sein: Die Ausbildung ist ziemlich vielfältig, also sollte man flexibel sein und nicht nur eine Sache machen wollen
· Zuverlässigkeit: Termine und Deadlines einhalten ist wichtig – sowohl im Betrieb als auch in der Berufsschule
Interview mit Morice
Ich habe gezielt nach einer Ausbildungsstelle im Bereich der Fachinformatiker für Systemintegration in meiner Umgebung gesucht. Die Stelle habe ich bei der Agentur für Arbeit entdeckt und mich daraufhin beworben. Das anschließende Bewerbungsgespräch lief gut, sodass ich letztlich angenommen wurde.
Ich wollte mir ein Wissen über IT aneignen – von Software bis Hardware, damit ich im Berufs- und Privatleben bei Fragen helfen kann. Besonders wichtig war mir auch, den Umgang mit Fehlern und Herausforderungen zu lernen. Wichtig war für mich ein gutes Teamklima. Diese Wünsche wurden alle erfüllt, auch wenn ich noch viel zu lernen habe.
Am spannendsten fand ich bisher praktische Aufgaben mit Hardwarebezug, sowie selbstständiges Lösen schwererer Aufgaben. Weniger Spaß machen mir Aufgaben bei denen ich lange auf Rückmeldungen warten musste und ich in der Zeit nicht viel machen konnte.
Von Beginn an wurde ich freundlich in das Team aufgenommen. Alle Kollegen sind hilfsbereit, stehen für Fragen bereit und sind auch mal für einen Witz zu haben.
- Mein wichtigster Tipp: Hab keine Scheu Fragen zu stellen – auch wenn die Fragen einfach klingen.
- Eigne dir IT-Grundwissen an, um nicht in das kalte Wasser geschmissen zu werden und es einem nicht so kompliziert vorkommt.
- Außerdem ist es wichtig, dass man sich auf dich verlassen kann.
Interview mit Luisa
Auf das IPK an sich bin ich durch Interesse an einem Schülerpraktikum gekommen. Ich durfte dann zwei Praktika in zwei verschiedenen Arbeitsgruppen absolvieren. Dadurch wurde mir schnell klar, dass Biologielaborantin der Beruf ist, der mir von den Arbeiten her am besten gefällt. Somit habe ich mich nach meinem Abitur hier beworben.
Von der Ausbildung habe ich mir Abwechslung im Arbeitsalltag (nicht nur den ganzen Tag im Labor oder am Computer verbringen) und Arbeiten die mir Spaß machen gewünscht. Beides wurde im Großen und Ganzen erfüllt, natürlich sind immer Tätigkeiten dabei, die einem nicht so viel Spaß machen aber das ist ja kein Dauerzustand. Zudem findet die Ausbildung nicht nur ausschließlich hier am IPK statt. Durch verschiedene außerbetriebliche Praktika lernt man auch noch neben dem Bereich der Pflanzenwelt auch die Mikrobiologie, den humanmedizinischen Bereich, veterinärmedizinischen Bereich und weitere Teilgebiete kennen, in denen man als Biologielaborantin tätig werden kann.
Besonders viel Spaß hat mir die Arbeit an einem CRISPR-Projekt („Genschere“) gemacht, wobei das Ziel ist bestimmte Gen-Sequenzen in der Pflanze gezielt auszuschalten durch Austausch mit anderen Sequenzen. Dadurch kann die genaue Funktion des Gens untersucht werden.
Ab und zu gibt es natürlich auch mal ein paar Dinge, die sehr zeitaufwendig in der Bearbeitung sind, was auch mal eintönig werden kann. Jedoch gehört dies nicht zum Arbeitsalltag.
In den drei Arbeitsgruppen, in denen ich bisher war, habe ich mich immer gut betreut gefühlt. Mir wurde nach der Einarbeitungsphase teilweise sogar ein eigenes Projekt gegeben, welches ich fast ausschließlich alleine betreuen konnte. Alle Mitarbeiter am IPK, die ich in meiner bisherigen Ausbildung kennenlernen durfte, waren alle sehr nett und immer freundlich.
Ich persönlich fand das Praktikumsangebot meiner Schule sehr sinnvoll, da man dadurch erst so richtig ein Gefühl dafür bekommt, wie ein richtiger Arbeitsalltag aussieht. Daher kann ich jedem empfehlen, der sich für die Ausbildung zum Biologielaboranten interessiert vorher ein Praktikum am IPK zu absolvieren, um zu sehen, ob dieser Beruf auch wirklich etwas für einen ist.
Interview mit Lilly
2019 hatte ich die Möglichkeit ein zweiwöchiges Praktikum am IPK zu absolvieren. Da ich mich bereits zuvor für biologische Forschung interessierte, half mir dieses Praktikum dabei, mich für den Beruf der Biologielaborantin zu entscheiden. In dem Praktikum erhielt ich einen umfassenden Einblick in die Arbeit am IPK und fühlte mich von Anfang an gut aufgehoben. Da im Jahr 2020 aufgrund der Corona-Pandemie keine Ausbildungsplätze angeboten wurden, entschied ich mich, zunächst mein Abitur zu absolvieren. Als 2024 Ausbildungsplätze ausgeschrieben wurden, bewarb ich mich selbstverständlich direkt – und etwa drei Monate später hatte ich mein erstes Vorstellungsgespräch und nach kurzer Zeit konnte ich meinen Ausbildungsvertrag unterschreiben.
Meine Erwartungen an die Ausbildung waren, dass sie abwechslungsreich gestaltet ist und ich die Möglichkeit bekomme, viele verschiedene Tätigkeiten auszuprobieren. Außerdem war mir wichtig, dass ich mich jederzeit an jemanden wenden kann, wenn es Probleme oder Unsicherheiten gibt – und genau das wird hier am IPK erfüllt. Da es sich um eine duale Ausbildung handelt, wechsle ich regelmäßig zwischen zwei Wochen Berufsschule und etwa vier Wochen praktischer Arbeit am IPK. Während meiner Zeit im IPK durchlaufe ich alle sechs bis neun Monate verschiedene Arbeitsbereiche, um die vielfältigen Möglichkeiten und Aufgabenfelder in den Laboren des Instituts kennenzulernen. Dabei stehen mir zwei feste Ausbilder zur Seite, an die ich mich jederzeit wenden kann. Zusätzlich finde ich Unterstützung bei den Kolleginnen und Kollegen in der jeweiligen Arbeitsgruppe, in der ich gerade eingesetzt bin.
Besonders gut gefallen hat mir die Arbeit an den Mikroskopen in der Arbeitsgruppe „Strukturelle Zellbiologie“. Dort werden pflanzliche Proben für mikroskopische Untersuchungen vorbereitet – sowohl für die eigene Gruppe als auch für andere Forschungsbereiche. Es hat mir großen Spaß gemacht, den Umgang mit verschiedenen Mikroskopen zu erlernen, hochwertige Zellschnitte anzufertigen und diese fotografisch zu dokumentieren. Auch die Arbeit im Labor finde ich spannend. Zwar erfordert sie mitunter viel Ausdauer und Konzentration über längere Zeiträume, doch gerade das macht sie für mich besonders reizvoll.
Als Auzubi ist man hier gut aufgehoben. Man wird nie allein gelassen, und jede gestellte Frage wird ernst genommen und beantwortet. Auch wenn man „nur“ Azubi ist, gehört man dennoch zu einer großen Gemeinschaft, die gemeinsam die Pflanzenforschung voranbringt.
Schon während man neue Tätigkeiten erlernt, ist man aktiv in Projekte eingebunden und trägt zur Forschung bei. Dabei lernt man, seine Aufgaben eigenständig zu planen und verantwortungsvoll umzusetzen.
Mir wird oft gesagt: Es gibt keine dummen Fragen. Wenn du dir bei etwas unsicher bist oder nicht weiterweißt, zögere nicht, nachzufragen. So lassen sich Fehler vermeiden und wertvolle Zeit sparen. Auch wenn es unangenehm erscheint, mehrmals nachzufragen – das ist völlig in Ordnung. Wir sind Auszubildende und befinden uns in einer Lernphase, in der Fragen jederzeit erlaubt und erwünscht sind.
Für diesen Schritt brauchen wir noch eine gültige E-Mail-Adresse von dir. Bitte hinterlege sie in deinem Account.
Schon erledigt.